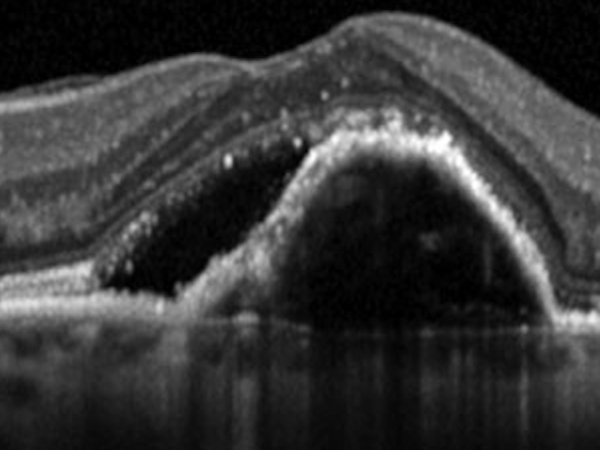
esame oct in uveite posteriore

UVEITE
L'uvea è molto sensibile a processi infettivi e infiammatori perché è il tessuto con più vasi sanguigni di tutto l'organismo.
Cosa è l'uveite
L'uveite è una infiammazione dell'uvea, membrana che ricopre l'interno del bulbo oculare.
L'uveite è una delle cause di cecità più importanti nel mondo.
L'infezione dell'uvea provoca una grave perdita di vista perché in strato contatto con la retina.
L'uveite è una delle cause di cecità più importanti nel mondo.
L'infezione dell'uvea provoca una grave perdita di vista perché in strato contatto con la retina.


Perché si produce
Esitono diversi fattori che provocano l'uveite:
Malattie infettive come la toxosplasmosi, possono essere la causa più comune di uveite: corioretinite infettiva. Questo processo provoca una graduale distruzione della retina e della macula, provocando una importante perdita di vista in modo irreversibile.
Malattie ossee o reumatiche di origine infiammatori o degenerativa, che colpiscono soprattutto i giovani.
Malattia autoimmune dovuta a virus, germi o fattori ambientali, come la sarcoidosi.
Traumatismi o determinate mutazioni genetiche associate con la malattia.
Malattie infettive come la toxosplasmosi, possono essere la causa più comune di uveite: corioretinite infettiva. Questo processo provoca una graduale distruzione della retina e della macula, provocando una importante perdita di vista in modo irreversibile.
Malattie ossee o reumatiche di origine infiammatori o degenerativa, che colpiscono soprattutto i giovani.
Malattia autoimmune dovuta a virus, germi o fattori ambientali, come la sarcoidosi.
Traumatismi o determinate mutazioni genetiche associate con la malattia.

Come si manifesta
I sintomi di uvette sono differenti a seconda della zona di uvea affetta.
Uveite anteriore, si nota una maggiore sensibilità alla luce (fotofobia), arrossamento dell'occhio, vista offuscata e dolore oculare.
Uveite posteriore, non è associato dolore ma solo perdita di vista.
Le uveiti non possono essere diagnosticate fino a che non compaiono dei segni clinici. Con i primi sintomi è importante sottoporsi ad una visita specialistica.
Uveite anteriore, si nota una maggiore sensibilità alla luce (fotofobia), arrossamento dell'occhio, vista offuscata e dolore oculare.
Uveite posteriore, non è associato dolore ma solo perdita di vista.
Le uveiti non possono essere diagnosticate fino a che non compaiono dei segni clinici. Con i primi sintomi è importante sottoporsi ad una visita specialistica.

Come si può prevenire
L'uveite è una delle patologie oculari più correlata con altre malattie dell'organismo.
Normalmente è necessaria la collaborazione con un medico internista che possa completare lo studio e il trattamento della malattia che provoca l'uveite. In alcuni casi il trattamento di queste patologie o infezioni possono aiutare a prevenire le uveiti.
Normalmente è necessaria la collaborazione con un medico internista che possa completare lo studio e il trattamento della malattia che provoca l'uveite. In alcuni casi il trattamento di queste patologie o infezioni possono aiutare a prevenire le uveiti.
DIAGNOSTICA
Esame oculare di base
Un esame oculare basico eseguito con lampada a fessura, strumento in dotazione in tutti gli studi oftalmologici, permette di diagnosticare la presenza di una infiammazione e le strutture oculari maggiormente interessate.
Successivamente saranno necessari esami strumentali per una corretta diagnosi.

OCT
L’OCT, senza l’utilizzo di mezzi di contrasto, permette, attraverso l’uso di una sonda laser ad infrarossi, di ricostruire l’anatomia della retina nella regione maculare.
Nelle forme di uvette posteriore è dirimente per la diagnosi di edema maculare.
Nelle forme di uvette posteriore è dirimente per la diagnosi di edema maculare.
Fluorangiografia retinica
La fluorangiografia è un esame fondamentale per lo studio della retina. Si esegue iniettando in vena un mezzo di contrasto e scattando poi delle foto con uno strumento specifico.
Nelle forme di uvette posteriore è indispensabile per individuare le aree retiniche maggiormente affette dalla patologa infiammatoria.
Nelle forme di uvette posteriore è indispensabile per individuare le aree retiniche maggiormente affette dalla patologa infiammatoria.

TRATTAMENTO
Collirio antinfiammatorio
Utile per trattare le forme di uveiti anteriori.
le terapie prevedono la somministrazione di colliri cortisonici e cicloplegici per ridurre l'infiammazione e la sintomatologia dolorosa.
La terapia può protrarsi anche per diversi mesi.
le terapie prevedono la somministrazione di colliri cortisonici e cicloplegici per ridurre l'infiammazione e la sintomatologia dolorosa.
La terapia può protrarsi anche per diversi mesi.

Cortisonici
Utili nel trattamento delle forme di uveite posteriore. Possono essere somministrati per bocca o tramite iniezioni intorno all'occhio.
Ultimamente è stato approvato un impianto di cortisone a rilascio graduale da iniettare direttamente all'interno dell'occhio.
Esplora l'iniezione intravitreale di antinfiammatori
Ultimamente è stato approvato un impianto di cortisone a rilascio graduale da iniettare direttamente all'interno dell'occhio.
Esplora l'iniezione intravitreale di antinfiammatori

Intervento chirurgico
utile nel correggere le complicazioni associate all'infiammazione uveitica come la cataratta, il glaucoma (che colpiscono il segmento anteriore), il distacco di retina, le opacità vitreali o l'edema maculare ( che colpiscono il segmento posteriore).
Esplora la vitrectomia
Esplora la vitrectomia









